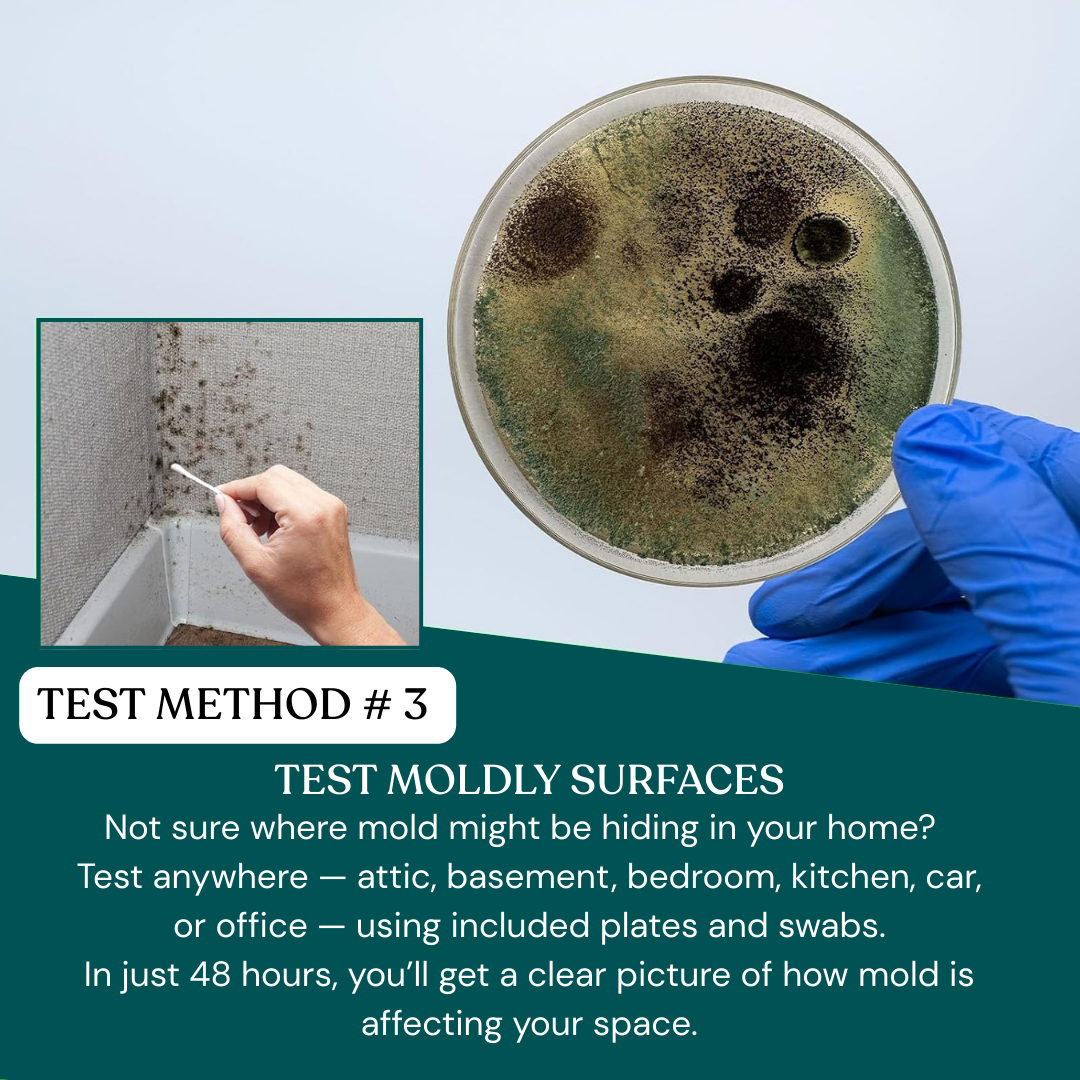
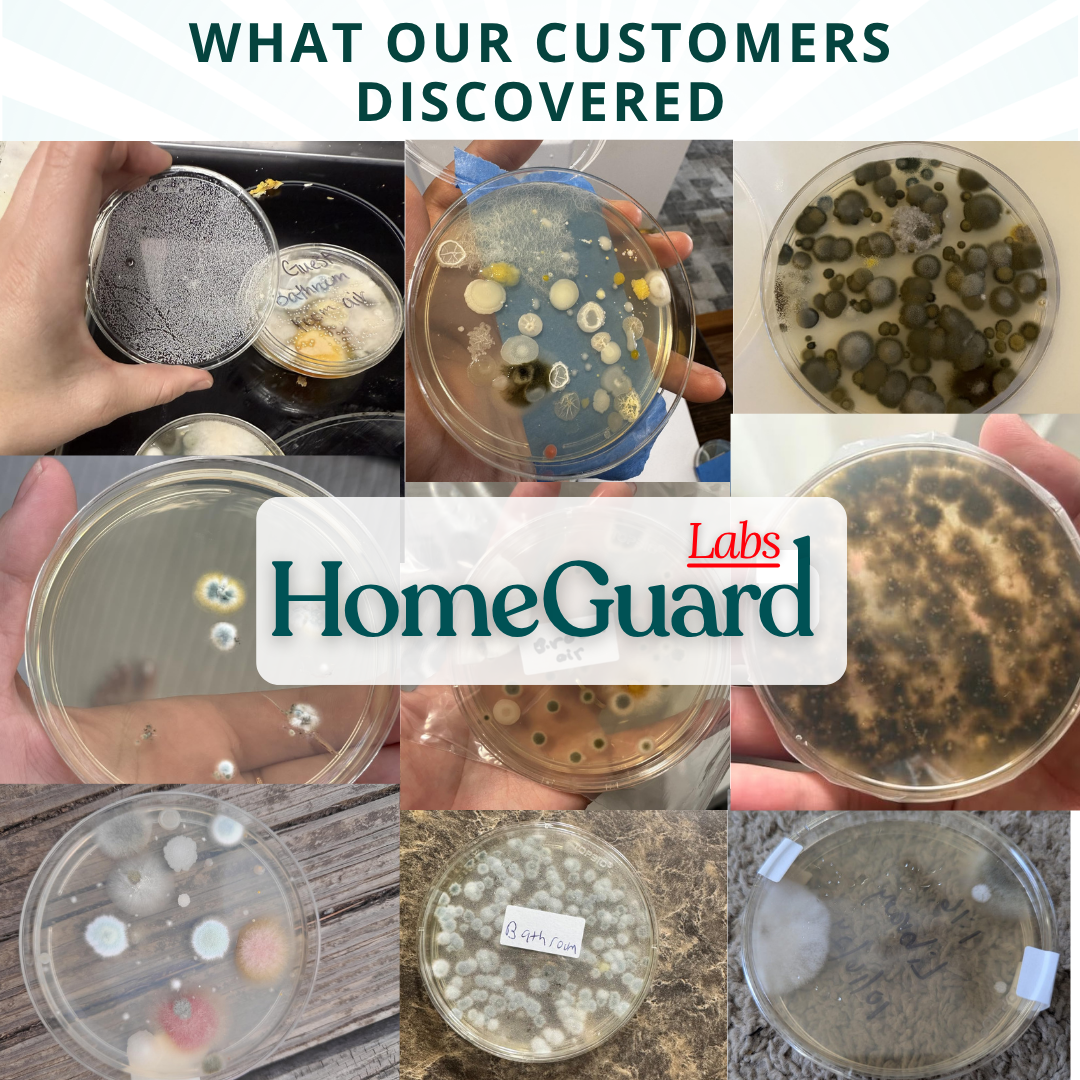

The patented mold test Kit
by homeguard
Designed for homeowners who want answers they can actually understand.
Couldn't load pickup availability










Nope. Everything happens right at home
no shipping, no waiting weeks for results, no lab fees.
Here's how it works: Open the test plate for 1 hour in the room you want to check. Seal it. Wait 48-72 hours. The results appear right on the plate.
You'll see exactly what's growing in your air no middleman, no confusion, no extra costs. The included guide shows you what healthy air looks like vs. contaminated air, plus clear next steps based on what you find.
Thousands of families have done this exact test at home. You can too.
Most people start seeing visible growth within 48 hours.
You place the plate, follow the steps in the guide, then check it as it develops. No waiting weeks for complicated reports.
You'll see exactly what's growing in your home not a number, not a vague report, but actual visual proof.
After 48 hours, compare the dishes side by side. If your bedroom dish is covered in colonies but your living room dish is nearly clear, you know where the problem is. If multiple rooms look heavy compared to outside, you know it's a whole-home issue.
The included guide shows you what light, moderate, and heavy growth looks like, along with mold types and next steps depending on the mold found.
There are no harsh chemicals, no fumes, and no special equipment needed.
Just follow the printed instructions, keep the plates out of reach while they’re running, then close them when the test time is done.
HomeGuardLabs helps you uncover what’s happening in your home, without the confusion.
Our Mold Test Kit gives you a clear, visual way to compare rooms and spot heavy growth patterns and mold types, using the included step-by-step guide.
No complicated reports. No guessing.
Just an easy-to-use test that helps you feel confident about what you’re breathing and what to do next.

Real Customers, Real Results
"We had water damage 'fixed' months ago, but I never felt right after. Constant fatigue, headaches, my kids always congested.
This test showed heavy mold growth in the bedroom. The restoration company missed it.
Finally had proof after months of doctors telling me nothing was wrong. Wish I'd tested sooner."
SEE WHAT OTHERS DISCOVERED









Over 10,000+ CUSTOMERS TRUST HOMEGUARD
See how customers use our kits to check the air they breathe.